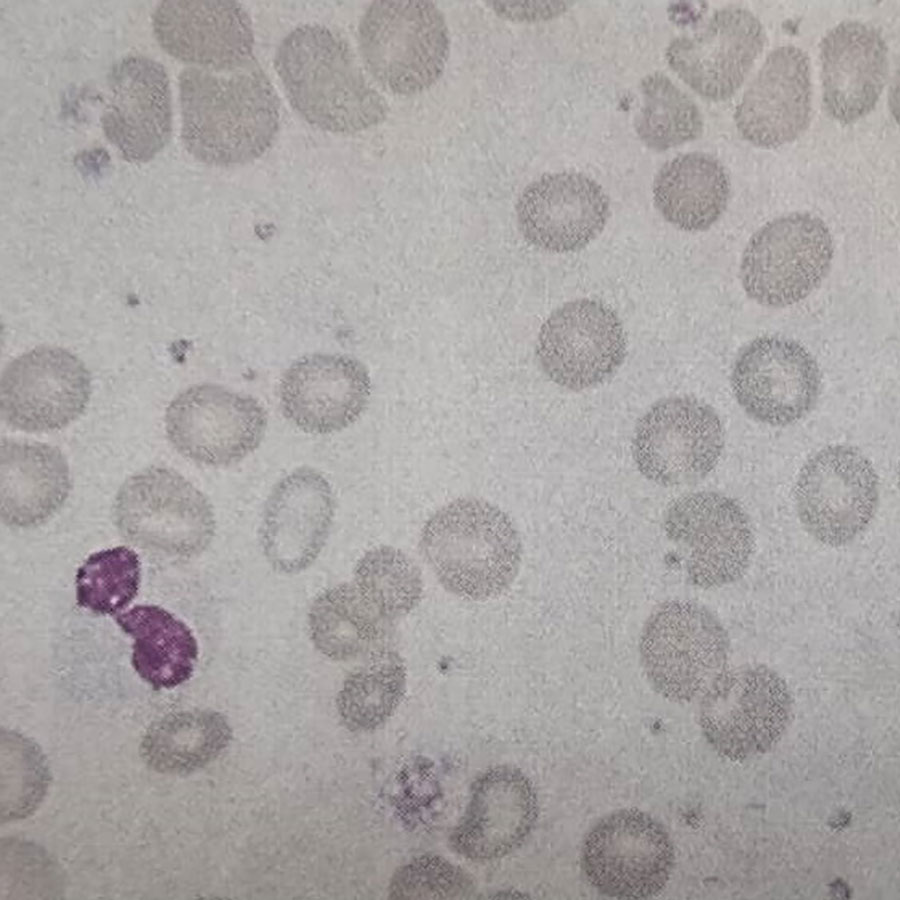
ظاهر گسترش خون محیطی بیمار

مطالعه موردی بیمار شماره 64، تشخیص شما چیست؟
شرح حال بیمار
یک زن ۸۲ ساله به مدت ۵ ماه به دلیل کمخونی پایدار (persisting anaemia) و ترومبوسیتوپنی (thrombocytopenia) تحت درمان بوده است.
نتایج شمارش کامل خون (Full Blood Count) او به شرح زیر است:
- هموگلوبین: 7.1 g/dL
- گلبول سفید: 1.3 × 10⁹/L
- نوتروفیلها: 0.4 × 10⁹/L
- لنفوسیتها: 0.4 × 10⁹/L
- بلاستها: 2٪
- پلاکت: 23 × 10⁹/L

سوالات و پاسخها
1. نظر شما در رابطه با ظاهر صورت بیمار چیست؟ (شکل 64a)
صورت بیمار دارای پیگمانتاسیون خاکستریرنگ است که ناشی از اضافهبار آهن به دلیل تزریقهای مکرر خون (transfusional iron overload) میباشد.
در آسپیراسیون مغز استخوان با رنگآمیزی پرلز (Perl’s stain) افزایش آهن مشاهده میشود (شکل 64c). بیوپسی ترفین مغز استخوان افزایش هموسیدرین را نشان میدهد (شکل 64d)
از دیگر عوارض اضافهبار آهن میتوان به موارد زیر اشاره کرد:
- اختلالات غدد درونریز (مانند دیابت)
- بیماریهای کبدی
- کاردیومیوپاتی
همچنین این بیمار به دلیل ترومبوسیتوپنی دچار اکیموز گسترده (کبودیهای وسیع پوستی) نیز بوده است (شکل 64e)
2. نظر شما در مورد ظاهر گسترش خون محیطی بیمار چیست؟ (شکل 64b)
گسترش خون محیطی بیمار هیپوسگمانتاسیون هسته نوتروفیلها (فرم های سودو-پلگر–هیوت) به همراه کاهش گرانولهای سیتوپلاسمی نوتروفیلها ( (hypogranularity، وجود تعدادی بلاست و آنیزوسیتوز پلاکتی و گلبولهای قرمز (تفاوت در اندازه سلولها) را نشان میدهد.
3. تشخیص شما چیست؟
تشخیص میلودیسپلازی (Myelodysplasia / Myelodysplastic Syndrome – MDS) است.
این بیماری با سیتوپنیهایی که بیش از یک رده سلولی را درگیر میکنند مشخص میشود، در حالی که مغز استخوان معمولاً سلولار (پر سلول) است. این وضعیت نشاندهنده اختلال در بلوغ سلولی داخل مغز استخوان میباشد.
از دیگر ویژگیهای تیپیک میلودیسپلازی مگاکاریوسیتهای غیرطبیعی و وجود بلاستها در خون یا مغز استخوان است. (شکل 64f)
4. پیشآگهی (Prognosis) این بیماری چگونه است؟
میلودیسپلازی معمولاً در افراد سالمند دیده میشود، هرچند امکان بروز آن در هر سنی وجود دارد، و یک اختلال منشأگرفته از سلولهای بنیادی خونساز است. در بسیاری از بیماران، تغییرات سیتوژنتیکی مشاهده میشود که شایعترین آنها درگیری کروموزومهای ۵ و ۷ است. در ایجاد این اختلالات پیشلوسمیک، جهشهای ژنتیکی مؤثر بر رشد و تمایز سلولهای بنیادی خونساز نقش دارند، اگرچه علت دقیق بیماری هنوز مشخص نیست. در برخی موارد، بیماران سابقه دریافت شیمیدرمانی سرکوبکننده مغز استخوان برای بدخیمیهای غیرمرتبط داشتهاند. پیشآگهی بیماری به شدت کاهش سلولهای خونی (سیتوپنیها) که خطر بروز عوارض نارسایی مغز استخوان را تعیین میکند و همچنین به درصد بلاستها در خون و مغز استخوان که میزان خطر تبدیل به لوسمی را نشان میدهد، وابسته است. بیماران مبتلا به مراحل اولیه میلودیسپلازی، مانند کمخونی مقاوم به درمان با یا بدون وجود سیدروبلاستهای حلقوی، ممکن است به درمان خاصی نیاز نداشته باشند و بقای متوسط آنها حدود ۴ تا ۶ سال است. در مقابل، بیمارانی که به لوسمی میلومونوسیتیک مزمن یا کمخونی مقاوم به درمان همراه با افزایش بلاستها (RAEB) مبتلا هستند، معمولاً بقای متوسطی در حدود یک سال دارند. در مواردی که بیش از ۲۰ درصد سلولهای مغز استخوان را بلاستها تشکیل دهند (RAEB در حال تبدیل) یا درصد بلاستها به ۳۰ درصد برسد که معادل لوسمی میلوئید حاد (AML) است، در صورت توانایی بیمار برای تحمل درمانهای شدید، باید درمانهای اختصاصی AML آغاز شود.




